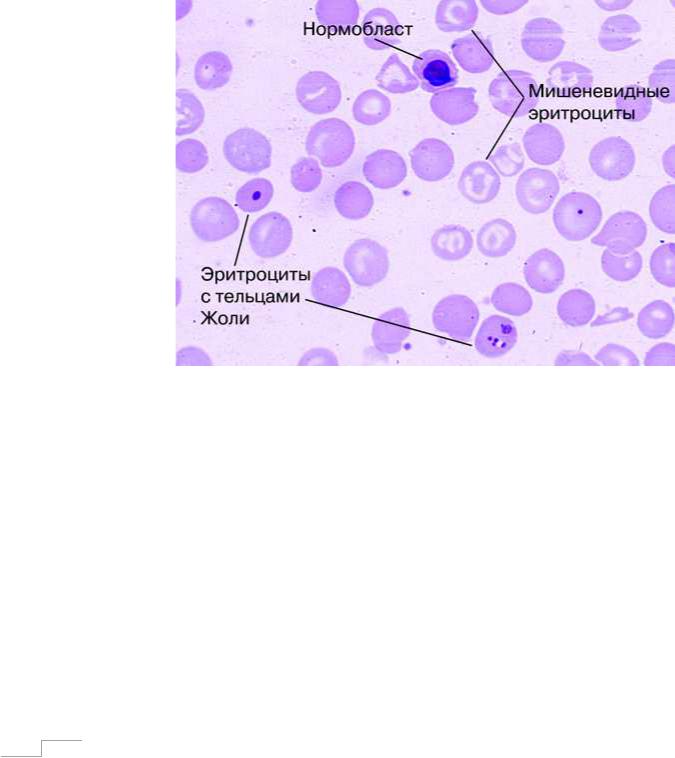

Материал: blood4

Контрольные задания к разделу II.2
1.Анемия при хронических заболеваниях связана с: А) Дефицитом железа Б) Нарушением реутилизации железа из макрофагов
В) Нарушением продукции эритропоэтина Г) Нарушением синтеза протопорфирина
2.Лабораторные проявления анемии при хронических заболеваниях: А) Сывороточное железо снижено Б) ОЖСС повышена В) ОЖСС снижена
Г) Сывороточный ферритин повышен Д) Сывороточный ферритин понижен
3.Для лечения анемии при хронических заболеваниях применяют: А) Препараты железа Б) Рекомбинантный эритропоэтин
В) Трансфузии эритроцитарной массы Г) Препараты витаминов группы В и фолиевой кислоты
4.Как изменяется уровень трансферрина при железодефицитной и железоперераспределительной анемии?
5.Дайте заключение по следующим гемограммам:
Гемоглобин – 105 г/л, эр. – 4,2×*1012/л, ретикулоциты – 6‰; Тромбоциты 209×*109/л, Лейкоциты – 8,9×*109/л, П – 8, С – 69, Э – 1, Б – 1, Л – 20, М – 1 СОЭ - 34 мм/час.
В мазке: гипохромия эритроцитов ++, микроцитоз ++.
Гемоглобин – 87 г/л, эр. – 3,40×*1012/л, ретикулоциты – 7‰; Тромбоциты 288×*109/л, Лейкоциты – 6,4×*109/л, П – 1, С – 79, Э – 1, Б – 1, Л – 19 СОЭ - 38 мм/час.
В мазке: гипохромия эритроцитов +++, микроцитоз +++.
6.Какие существуют принципиальные отличия характера миелограммы при железоперераспределительной анемии и железодефицитной анемии?
7.По каким параметрам в общем анализе крови возможно отличить железоперераспределительную анемию от железодефицитной анемии?
30

8. Клиническая задача.
Молодая женщина стала жаловаться на постоянный мучительный кашель без мокроты, повышение температуры тела 37,5-38С, увеличение надключичных лимфоузлов и увеличение нижней трети шеи, общую слабость.
Из анамнеза: данные жалобы беспокоят около полугода, в течение последнего времени усилились. Пациентка часто болеет простудными заболеваниями, отмечает также снижение массы тела около 3-4 кг. в течение 3 месяцев.
Объективно: общее состояние средней тяжести. Сознание ясное. Кожа и видимые слизистые бледные, чистые, влажные. Пальпируемые надключичные лимфатические узлы увеличены, безболезненные. Мышечная система развита умеренно, мышечная сила и тонус сохранены. Рост – 170 см, вес – 66 кг. Отеков нет. ЧД – 19 в минуту. Перкуторный звук легочный. Дыхание с жестковатым оттенком, особенно справа. Пульс одинаковый наобеих руках с частотой 82 в мин., ритмичный, удовлетворительного наполнения, не напряжен. АД – 110/60 мм.рт.ст. Перкуторно границы сердца не изменены. Тоны сердца не приглушены, ритм правильный. Живот мягкий, безболезненный. Печень и селезенка не пальпируются. Щитовидная железа не увеличена. Дизурии нет. Симптом Пастернацкого отрицательный с обеих сторон.
Общий анализ крови: Эритроциты – 3,2*1012/л, гемоглобин – 90,0 г/л,
Анизохромия+, микроцитоз++. Тромбоциты – 180,0 Г/л.
Лейкоциты – 8,0 Г/л, палочкоядерные – 10%, сегментоядерные - 70%, лимфоциты – 20%. СОЭ–40 мм/ч.
Анализ мочи общий.
Реакция нейтральная, уд. вес 1013, белок – 0,078г/л, эп. кл. плоские – 1-2 в п. зр., лейкоциты – 3-4 в п. зрения, эритроциты – 2 - 3 в п. зрения.
Анализ крови биохимический: Креатинин – 105,3 мкмоль/л. Общий белок – 60,3 г/л. Билирубин прямой – 2,0 мкмоль/л, непрямой – 11,5 мкмоль/л. АСТ – 0,22 ммоль/л, АЛТ – 0,19 ммоль/л. Калий – 3,9 ммоль/л, натрий – 139,2 ммоль/л. Сахар крови – 4,8 ммоль/л.
Рентгенологическое исследование органов грудной полости: в правом легком в S2 – очаг Гона. Резко расширена верхняя треть средостения со смещением трахеи; в правом легком очаги инфильтрации снечеткими границами без «дорожки».
Компьютерная томография органов грудной полости:
Конгломерат в средостении состоит из увеличенных лимфатических узлов.
Вопросы:
1.Сформулируйте клинический диагноз и дайте его обоснование.
2.Какие дополнительные обследования, необходимо провести для уточнения диагноза?
3.С чем связаны изменения в показателях общего анализа крови у данного пациента?
4.Проинтерпретируйте изменения в биохимических показателях
31

II.3 Талассемия
Талассемия является единственной гипохромной анемией из группы гемолитических анемий. Даная нозология связана с уменьшением числа глобиновых цепей в структуре гемоглобина, что обусловлено врожденным генетическим дефектом. При этом могут затрагиваться различные цепи глобина (α, β, γ, δ), в зависимости от чего выделяют несколько форм талассемии, однако наиболее часто встречающиеся из них - следующие:
∙α-талассемия;
∙β-талассемия (при гетерозиготном поражении формируется малая талассемия, при гомозиготном – большая (болезнь Кули));
∙смешанные варианты.
Патологичные молекулы глобина, как уже отмечено, не способны формировать структуру нормального гемоглобина, они преципитируют друг с другом, откладываясь в виде специфических комплексов внутри эритроцита. Подобный факт ведет к сокращению жизни клеток, которые подвергаются преждевременному вне- и внутрисосудистому гемолизу. При тяжелом течении талассемии, когда адаптивные компенсаторные процессы не способны восстановить нормальный уровень эритроцитов и гемоглобина в организме, происходит формирование экстармедуллярных очагов кроветворения и эритроидная гиперпродукция. Все эти процессы приводят к выраженному нарушению обмена железа в организме с повышенным отложением его не только в эритроидных клетках, но и в других органах и тканях, в норме не являющихся депо железа. Неизбежно развивается гемохроматоз. Этому же способствует и применение хронических гемотрансфузий как метода терапевтической поддержки больных.
Клинически талассемия манифестирует анемическим синдромом,
выраженность которого, как правило, связана с формой данного заболевания.
Так, наиболее легко переносятся α- талассемия и β-талассемия при гетерозиготном поражении (малая талассемия), при этом часто такие
32

варианты могут протекать бессимптомно. Совершенно иная ситуация наблюдается при β-талассемии при гомозиготном поражении (большая талассемия, болезнь Кули), когда болезнь быстро прогрессирует с рождения и в короткие сроки приводит к декомпенсированным состояниям.
Особенностями клинической картины всех форм талассемии являются:
анемический синдром различной степени выраженности, часто с землисто-
желтушным оттенком кожи; гепатоспленомегалия; деформация фаланг пальцев (прямоугольные, двояковыпуклые); возможны язвенные поражения голеней; холелитиаз; отставание в росте и развитии; различные поражения внутренних органов за счет гемохроматоза (фиброз и цирроз печени,
кардиомиопатия с развитием сердечной недостаточности и др.), нарушение иммунологической резистентности организма.
Лабораторными диагностическими критериями талассемии являются:
∙гипохромная анемия различной степени;
∙в мазке крови обнаруживается микроцитоз, анизоцитоз, ядерные эритрокариоциты, мишеневидные эритроциты; могут появляться патологические включения (тельца Жолли) (рис.5).
∙ретикулоцитоз;
∙уровень лейкоцитов и тромбоцитов в норме, либо наблюдается их незначительное увеличение;
∙в миелограмме выражена эритроидная гиперплазия (возрастает количество сидерабластов, эритробласты приобретают базофильную пунктуацию);
∙сывороточное железо, трансферрин и ферритин повышены, общая железосвязывающая способность сыворотки снижена;
∙гипербилирубинемия за счет непрямой фракции;
∙прямая и непрямая пробы Кумбса положительны;
33
∙при количественном определении различных форм гемоглобина определяется повышенное содержание гемоглобина F при гомозиготной β-талассемии, гемоглобина А2 при гетерозиготной β-
талассемии, при α- талассемии подобное исследование не выявляет какой-либо патологии, поэтому данный диагноз ставится на основании исключения наличия других гипохромных микроцитарных анемий;
Рисунок 5. Мазок крови при талассемии
При рентгенологическом исследовании длинных трубчатых костей и костей черепа в них выявляется расширение губчатого вещества за счет истончения коркового слоя, а также обнаруживаются явления остеопороза
(рис. 6). У больных талассемией нарушается фосфорно-кальциевый обмен,
что ведет к резкому снижению фосфора в костной ткани. В некоторых случаях изменяется структура трубчатых костей кистей рук по типу
«кружевного» вида (рис 7).
34